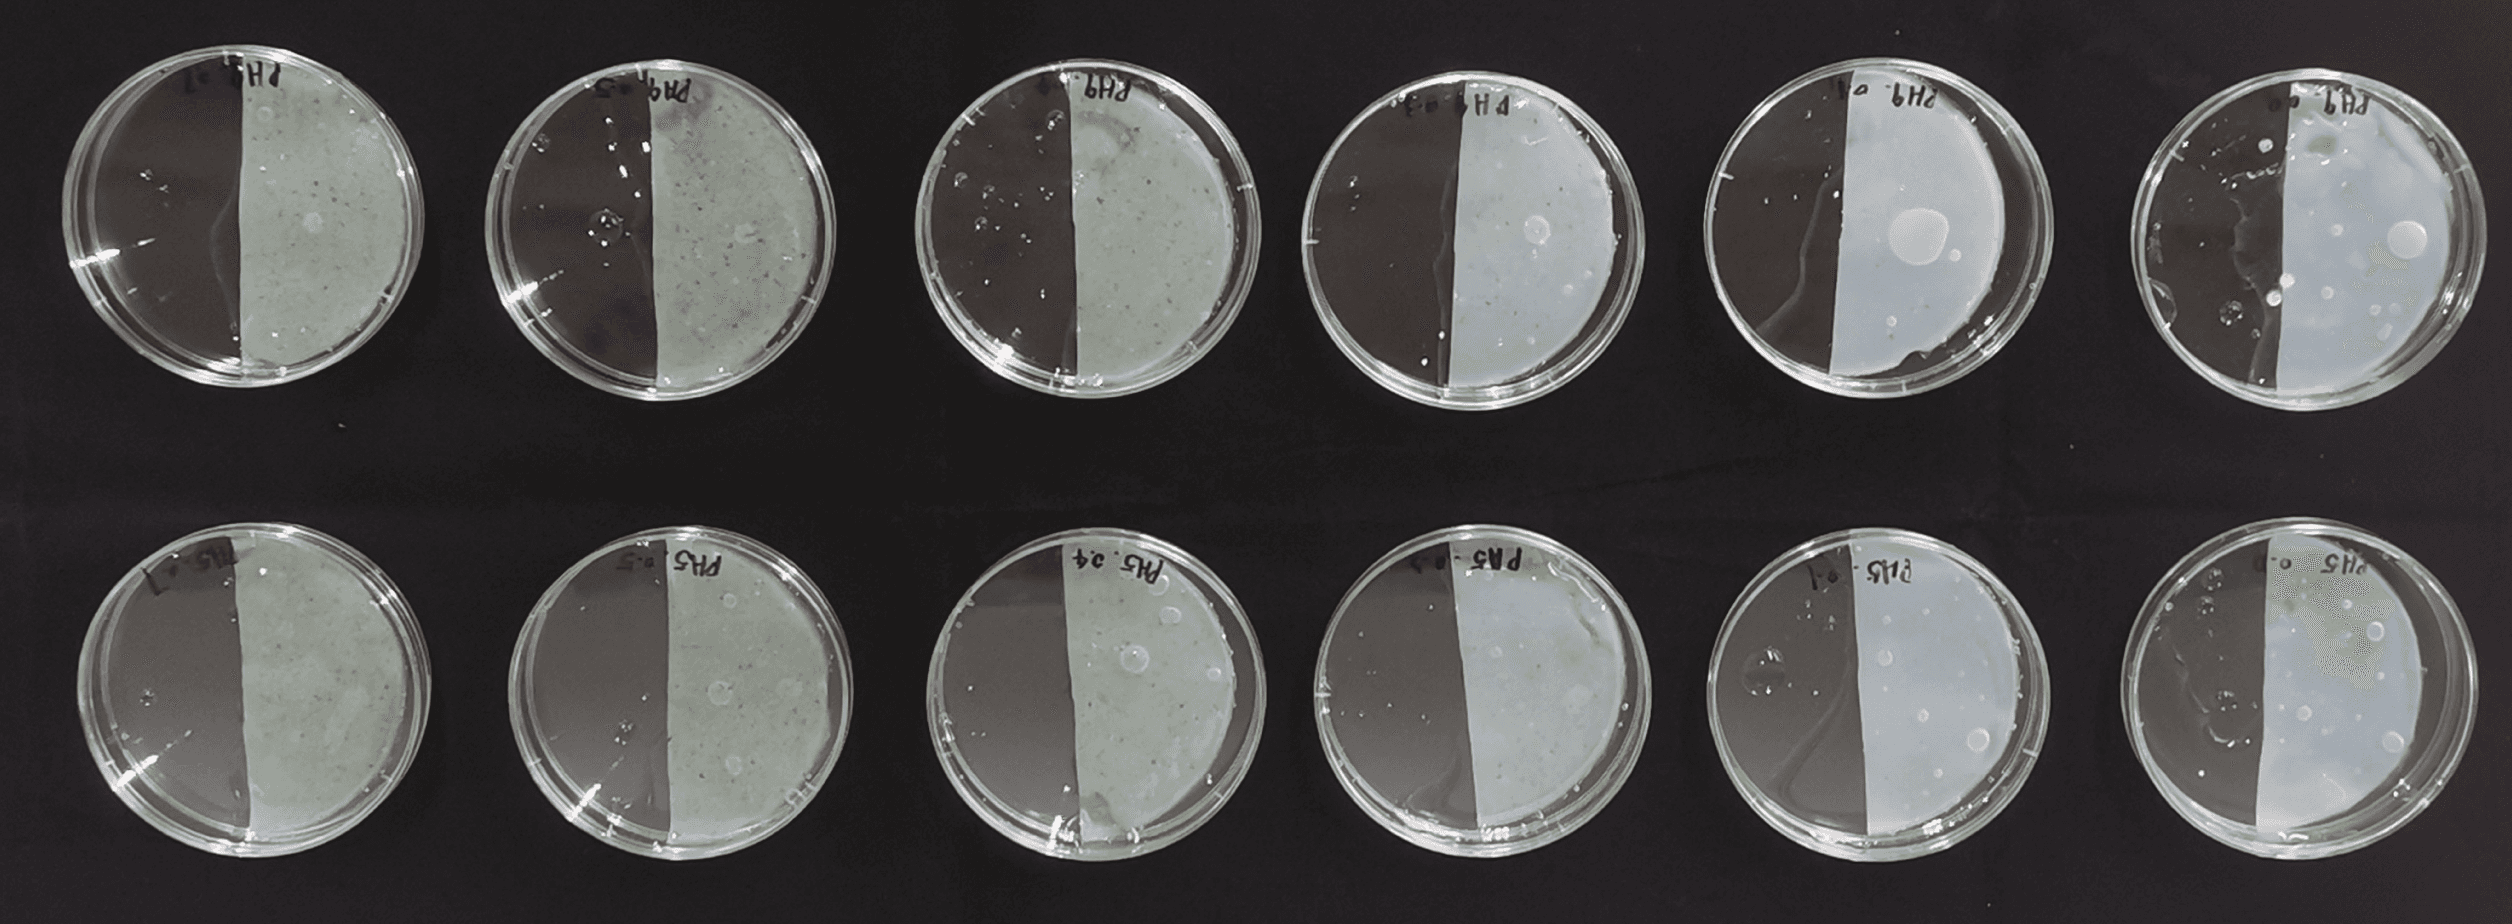

HONGXI DESIGN

NatureFlex
Biocomposite product design
for humidity regulation
NatureFlex
NatureFlex is a humidity regulation product, with its core being a biocomposite material of the same name. It provides a rapid response to high-humidity environments by capturing moisture from the air, all while operating with zero energy consumption. As a biodegradable material, NatureFlex can be fully decomposed by soil, offering the potential to become a sustainable alternative for current humidity regulation products.
Date
March - June 2024
Category
Sustainable System
Product Design
Key workds
Sustainable
Bio design
Material development
Other Information
Thesis Project
In collaboration with
Link Spider
Humidity Regulation - history and future

Why do we choose biomaterial as a new way to regulate humidity?

Goal
Explore the potential of bio-materials as a future method for humidity regulation
Theoretical path

BC properties development

Material Experiments


Molding Experiment
In this experiment the proportioning of master batches of different compositions and proportions is carried out and their molded state is observed. Among them, the masterbatch containing CNF was difficult to mold, while the sample with a BC content of 2.0%wt was the best for molding.


Material Water Response Experiment
This experiment determines the stability of the samples by immersing it in liquids of different pH levels and observing the change in weight of these samples.
Material Stability Experiment
This experiment determines the stability of the samples by immersing it in liquids of different pH levels (pH5 and pH9) and observing the change in weight of these samples. The results showed that the 0.3% sample has the least deviation from the standard value, demonstrating its better stability when exposed to different pH environments.
Experimental Result

Design Point - Folding Structure


Form Development

Product Design

Product Life-cycle

Reflections & Speculation
